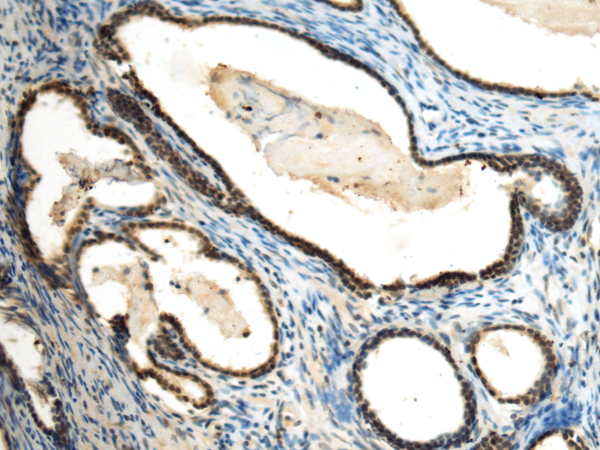

|
Background: |
Histone methyltransferase that specifically trimethylates 'Lys-9' of histone H3 using monomethylated H3 'Lys-9' as substrate. H3 'Lys-9' trimethylation represents a specific tag for epigenetic transcriptional repression by recruiting HP1 (CBX1, CBX3 and/or CBX5) proteins to methylated histones. Mainly functions in heterochromatin regions, thereby playing a central role in the establishment of constitutive heterochromatin at pericentric and telomere regions. H3 'Lys-9' trimethylation is also required to direct DNA methylation at pericentric repeats. SUV39H1 is targeted to histone H3 via its interaction with RB1 and is involved in many processes, such as cell cycle regulation, transcriptional repression and regulation of telomere length. May participate in regulation of higher-order chromatin organization during spermatogenesis. Recruited by the large PER complex to the E-box elements of the circadian target genes such as PER2 itself or PER1, contributes to the conversion of local chromatin to a heterochromatin-like repressive state through H3 'Lys-9' trimethylation. |
|
Applications: |
ELISA, WB, IHC |
|
Name of antibody: |
SUV39H2 |
|
Immunogen: |
Fusion protein of human SUV39H2 |
|
Full name: |
suppressor of variegation 3-9 homolog 2 |
|
Synonyms: |
KMT1B |
|
WB Recommended dilution: |
500-2000 |
|
WB Positive control: |
293T and K562 cell lysates |
|
WB Predicted band size: |
47 kDa |
|
IHC Recommend dilution: |
50-200 |
|
IHC positive control: |
Human prostate cancer |
|
ELISA Recommended dilution: |
5000-10000 |
|
SwissProt: |
Q9H5I1 |
購物車
幫助
021-54845833/15800441009
